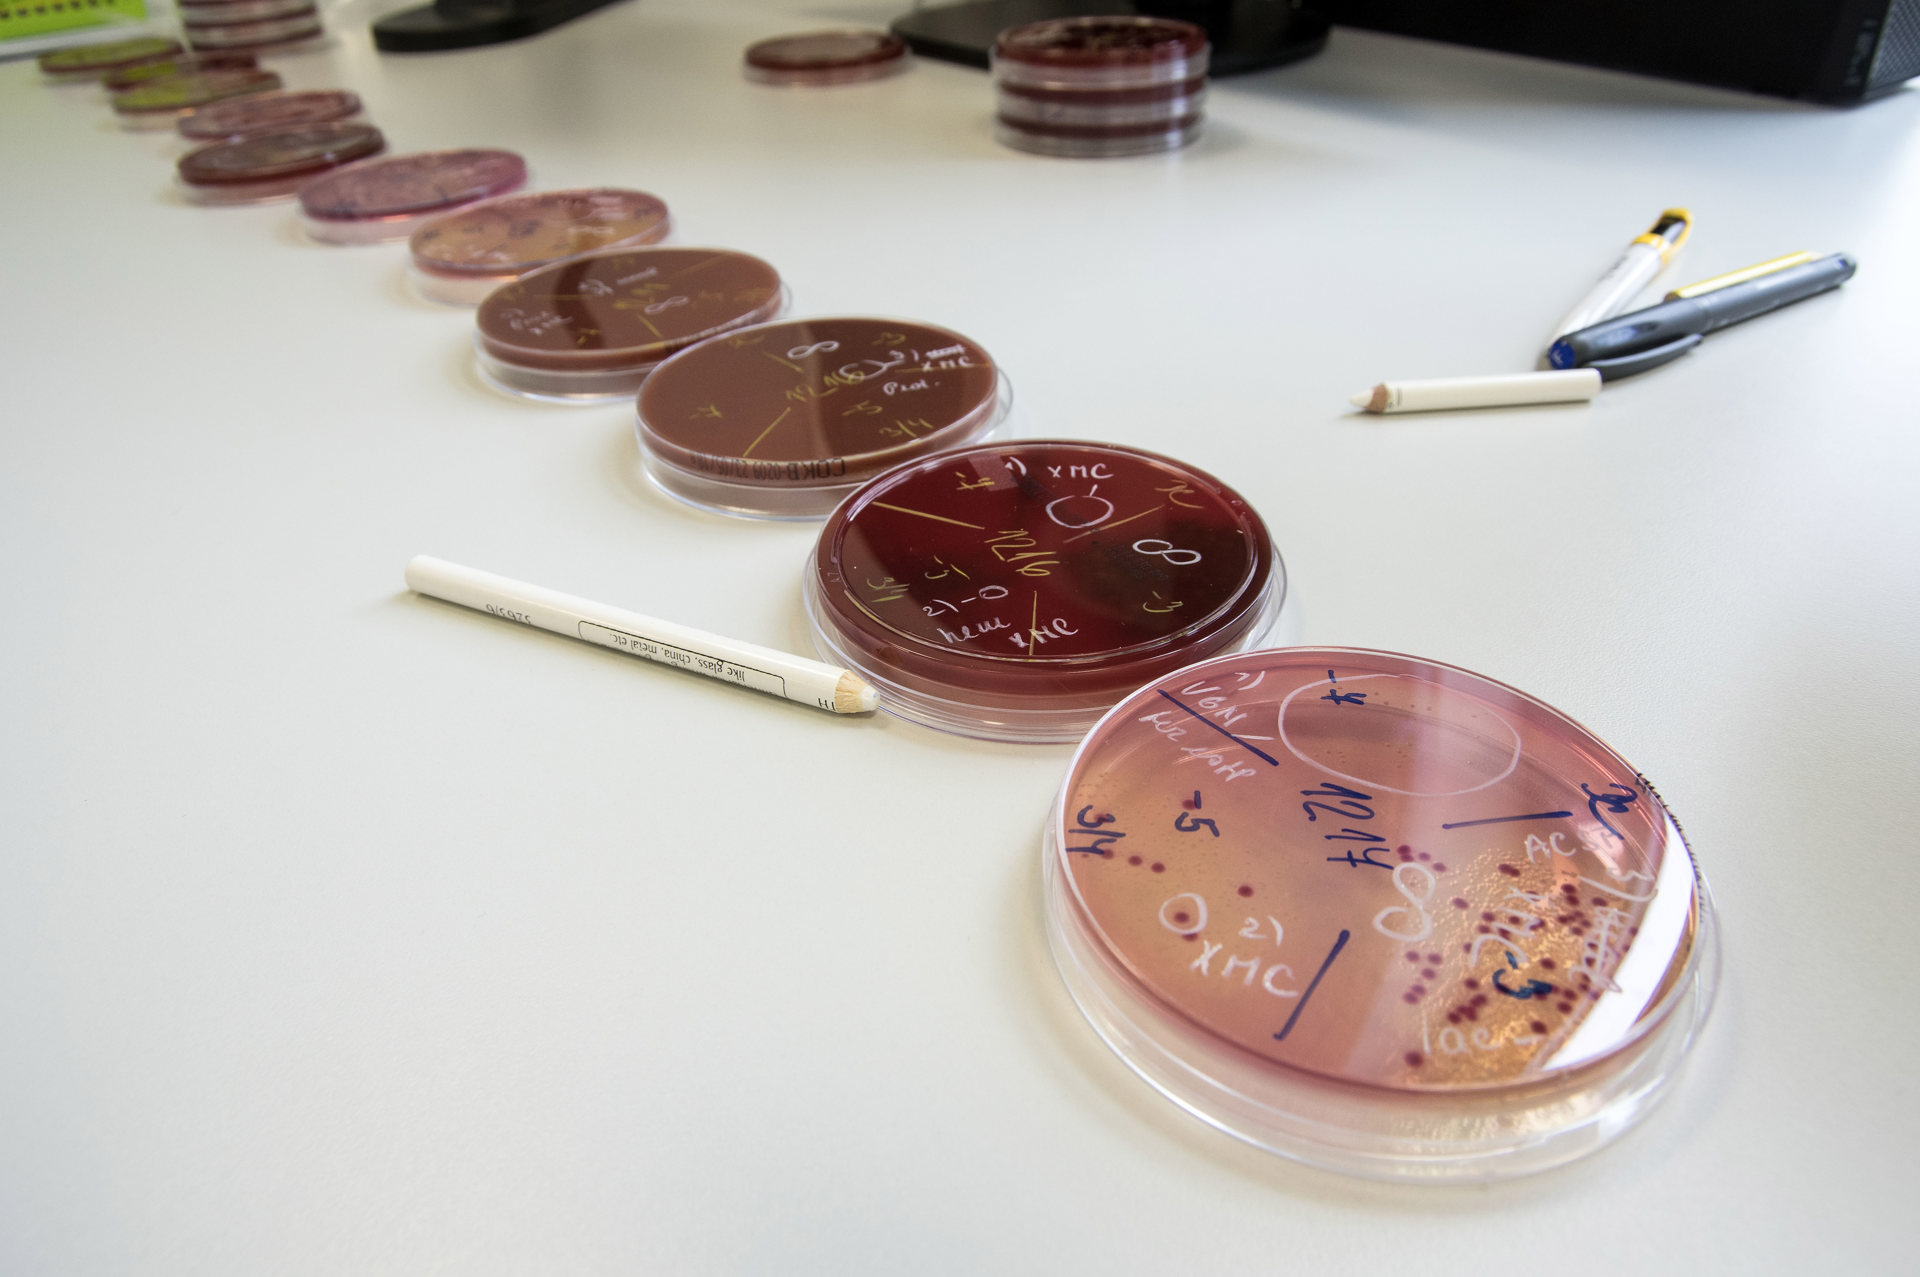

Laboratoř klinické mikrobiologie
Antibiotické středisko Brno
Antibiotické středisko je součástí laboratoře klinické mikrobiologie.
Umístění pracoviště
1. patro budovy
Telefonické konzultace
Po - Pá 9.00 - 15.00 hodin
So - Ne 10.00 - 14.00 hodin
Pohotovost
V případě potřeby volejte kdykoli.

Telefonické konzultace
Vedoucí antibiotického střediska
MUDr. Jana Juránková, Ph.D.
INFORMACE o středisku
ČINNOST LABORATORNÍ
Vyšetřování citlivostí bakterií na antibiotika se zvláštním zřetelem na diagnostiku neobvyklých rezistencí, polyrezistentních kmenů a produkce betalaktamáz.
ČINNOST KONZULTAČNÍ
konzultace antibiotické terapie nebo bakteriologických nálezů probíhají telefonicky. Telefonovat lze každý den včetně sobot, nedělí a svátků. Telefonické konzultace probíhají na tel. číslech: 735 158 297.
Do činnosti konzultační spadá i potvrzování žádanek na antibiotika, jejichž preskripce je možná jen po schválení antibiotickým střediskem.
SLEDOVÁNÍ NEMOCNIČNÍCH INFEKCÍ
Antibiotické středisko ve spolupráci s pověřenými lékaři a ústavními hygieniky jednotlivých nemocnic sleduje výskyt polyrezistentních kmenů, výskyt nemocničních infekcí, spolupracuje na tvorbě opatření, která zamezují šíření nemocničních nákaz.
ČINNOST EDUKAČNÍ
Po dohodě s vedením nemocnic antibiotické středisko připravuje semináře a přednášky s tématikou mikrobiologickou a s tématikou antibiotické terapie.